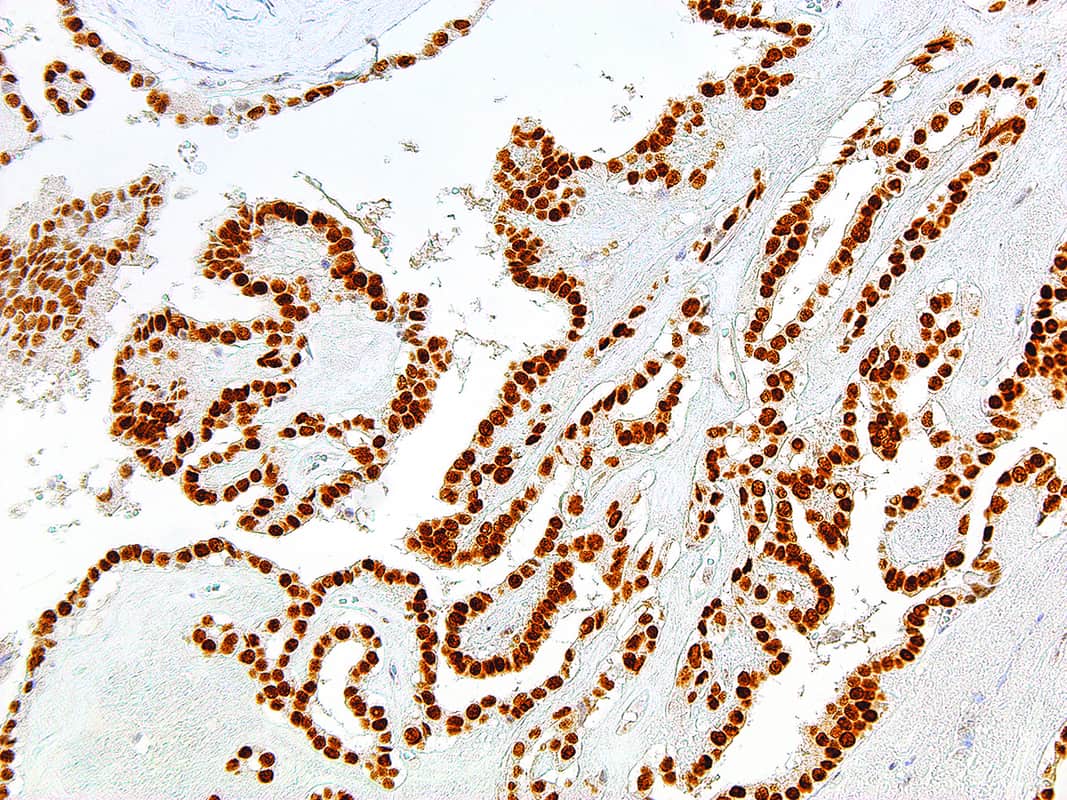
TTF-1 | Medical Supply Company

TTF-1
Thyroid Transcription Factor 1 (TTF-1) is present in diencephalon, lung, and thyroid. Anti-TTF-1 stains thyroid and thyroid-derived tumors, and is therefore used for distinguishing lung adenocarcinoma from germ cell tumors, malignant mesothelioma, and metastatic carcinomas from organs other than the thyroid. It is also useful for distinguishing small cell lung carcinoma from lymphoid infiltrates, and pulmonary from non-pulmonary adenocarcinomas in malignant effusions. The ability to distinguish between pulmonary and non-pulmonary adenocarcinomas is particularly useful in identifying tumors that have metastasized to the brain.
Specifications
| Clone | IHC414 |
| Source | Mouse Monoclonal |
| Positive Control | Lung Adenocarcinoma |
| Dilution Range | 1:100 – 1:400 |
Quantity
1.00
Select Volume
3 slides/package

Reviews
There are no reviews yet.